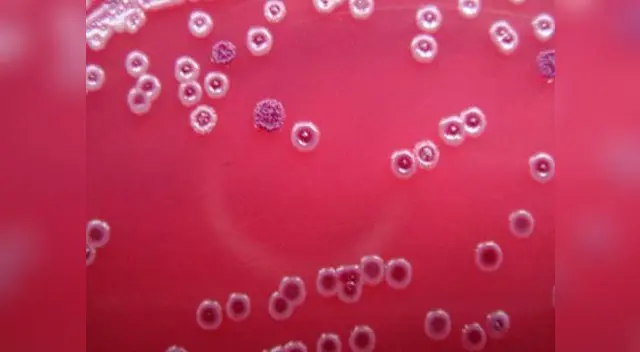
La enfermedad que podría acabar con la raza humana.

Ciencia: melioidosis, la enfermedad que amenaza a la vida humana
Un estudio realizado por expertos de la Universidad de Oxford indicaron que la infección de melioidosis podría expandirse por todo el mundo y terminar por afectar a la población.
Únete al canal de Whatsapp de El Popular- CONFIRMADO | Desde ESTA FECHA se reabrirá el SISTEMA DE GNV para los grifos del país según el Gobierno
- Confirmado | ¡Sequía DE 1 SEMANA en Lima! Corte de agua MASIVO este 12 al 18 de marzo: revisa los 52 sectores afectados SIN SERVICIO
Un estudio realizado por expertos de la Universidad de Oxford indicaron que la infección de melioidosis podría expandirse por todo el mundo y terminar por afectar a la población.
TAMBIÉN VEA: ¿Qué enfermedad podría alterar el embarazo en las mujeres?
La investigación, que fue publicado en la revista “Nature Microbiology”, especificó que el mal se extendió en 79 países y 34 de ellos no se ha documentado sobre la enfermedad.
El estudio preció que la bacteria “Burkholderia pseudomallei” se registra en suelos del sur y sudeste de Asia y del norte de Australia, así como en zonas no endémicas a través de la importación de animales infectados.
La melioidosis se contagia a través de la piel, los pulmones o por beber agua contaminada, puede ser complicado en su diagnóstico, pues sus síntomas son parecidos a la tuberculosis y la neumonía.
Las tasas de mortalidad incrementarían al 70 % si no existe un buen tratamiento para combatir la enfermedad.
Los científicos se asustaron porque cada año se registra 165 000 casos de melioidosis y 89 000 pueden ser mortales. Las cifras son similares a las del sarampión o las del dengue.
¿Qué pacientes están más expuestos? Cuidado aquellos que beban mucho alcohol, padezcan diabetes mellitus o enfermedad renal crónica.
Revisa todas las noticias escritas por el staff de redactores de El Popular.











